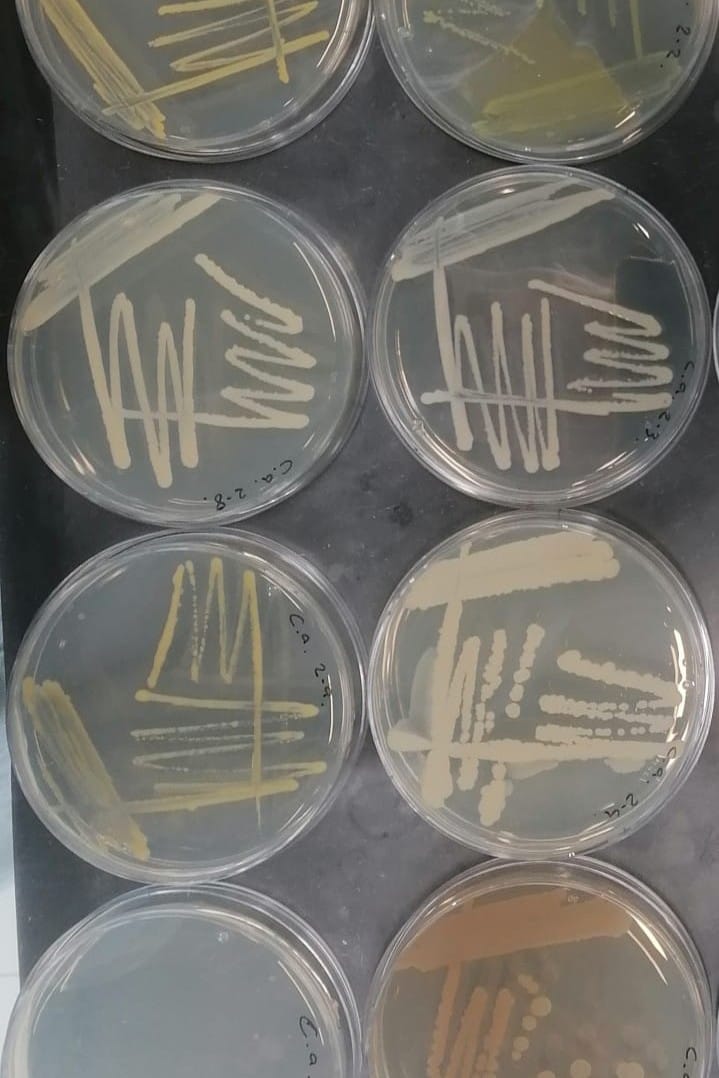

When seed scientists want to predict how long stored seeds can be kept before they lose their viability, and which batches might last longer than others, they do not simply wait for years to pass. Instead, they bring seeds into the laboratory and expose them to high temperatures and humidity. These conditions speed up ageing, causing damage that would normally take years to appear in just a few hours. Ultimately, the seed lots that tolerate these conditions are considered to be of higher quality than those that do not.
These experiments, known as accelerated ageing tests, have helped researchers uncover many of the changes that occur during storage, from shifts in seed chemistry to damage in cells and DNA. But one aspect has largely been overlooked: the seeds’ microbiome. Seeds are not just plant embryos—they also carry communities of microbes, especially bacteria, that can become some of the first colonists of a growing seedling. These microscopic partners may influence germination, supply useful compounds and help plants cope with stress and disease. For this reason, scientists are increasingly interested in how these microbial communities shape plant health and food security.
In a recent study published in Seed Science Research, Dr Nina Bziuk and colleagues set out to connect these two ideas. They asked whether accelerated ageing tests—widely used to assess seed quality—might also be altering the microbial communities of oilseed rape (Brassica napus), a crop valued as a major source of vegetable oil. In other words, could the way we test seeds also be changing the invisible life they carry?
To answer that question, the researchers used seeds from four plant genotypes grown at two field sites in Germany. Some seeds were left untreated, while others underwent an accelerated ageing test: 48 hours at 45°C under very high humidity. The seeds were then germinated to assess their performance.
Next, the team analysed the seed microbiome. They extracted DNA and sequenced part of the 16S rRNA gene—a commonly used genetic “barcode” that allows scientists to identify bacteria in mixed samples.
But they did not stop at DNA. The researchers also isolated live bacteria from a subset of seedlings and tested what these microbes could do. For example, they examined whether the bacteria could help plants access nutrients, produce iron-grabbing compounds or break down proteins—traits linked to plant health. By combining these approaches, the researchers could move beyond simply asking whether ageing harmed seeds—they could also identify which microbes survived, which were lost, and how these microbial shifts related to seed performance.
As expected in this kind of experiment, aged seeds performed worse. However, accelerated ageing did not simply reduce germination; it also reorganised their bacterial communities in clear and measurable ways. The biggest microbial change was a consistent decrease in bacterial diversity. Aged seeds and seedlings tended to host less varied bacterial communities, shifting towards groups dominated by Gram-positive bacteria, such as Bacillus and Tumebacillus, which are often better able to cope with harsh conditions. By contrast, several bacteria more associated with the untreated seeds, including Rhizobium, Sphingomonas and Methylobacterium, became less abundant. Another striking result was that aged seeds showed more variable bacterial communities than controls, suggesting that accelerated ageing made the microbiome less stable and predictable.

Perhaps most intriguing, the bacteria that increased after ageing were not automatically signs of healthier seeds. Higher levels of Bacillus and Tumebacillus were linked to poorer germination, even though some isolated bacteria from aged seedlings showed traits often considered beneficial for plants. That means ageing may favour hardy survivors, but not necessarily the balanced microbial community linked to good seed performance. The pattern was not completely uniform. Where the seeds had been grown and, to a lesser extent, which genotype they belonged to also influenced the microbiome. Even so, accelerated ageing was the strongest overall driver of change.
Taken together, the study suggests that when seeds age, they do not decline alone. Their microbial partners change too, and that may have real consequences for how well the next generation begins life. For seed science, this is an important shift in perspective. Storage has usually been judged by whether seeds stay alive and germinate, but this work argues that preserving the seed microbiome may also matter if we want vigorous, healthy plants after storage. While these artificial ageing conditions may not fully reflect how seeds and their microbiomes change during natural long-term storage, the findings highlight the need to rethink seed testing so that it tracks microbial health as well as seed viability. If that happens, seed banks and crop breeding programmes may one day aim not just to store seeds, but to store their invisible allies as well.
READ THE ARTICLE:
Bziuk N, Görtz S, Zur J, et al.. 2026. Accelerated aging caused diversity and specificity loss in the bacterial communities of Brassica napus seedlings. Seed Science Research: 1-15. https://doi.org/10.1017/s0960258526100099
Cover picture by Elena Beny.
